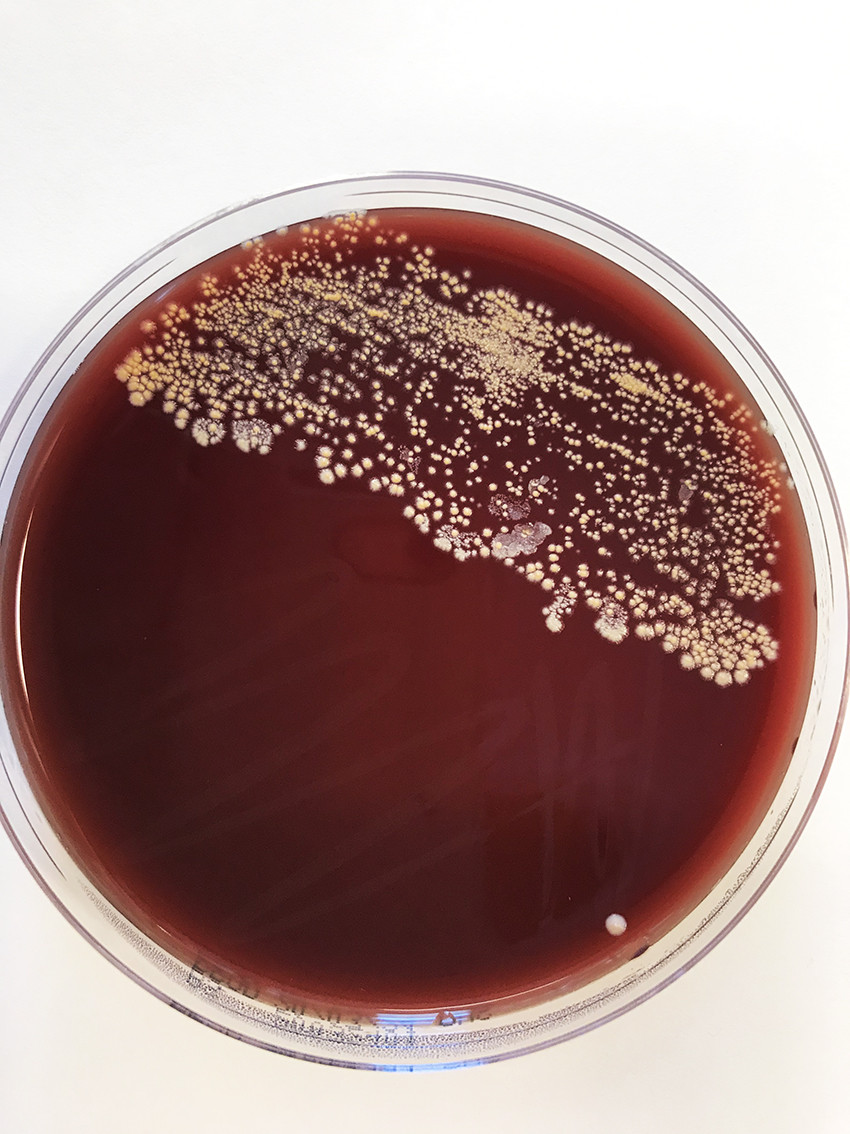
Figure 3 Inoculate from cerebral abscess on blood agar with pigmented colonies. Photo: Else Quist-Paulsen.

A man in his seventies with pleural effusion, knee pain and dysarthria following open heart surgery
Open heart surgery in an otherwise fit man was the start of 9 admissions in 6 months and a clinical course dominated by recurrent pleural effusion, dependent oedema and eventually a severe infection. Investigation and treatment were complex and required a multidisciplinary approach.
A man in his seventies with known aortic stenosis and persistent atrial fibrillation developed increasing dyspnoea on exertion. Progression of the aortic stenosis was found on echocardiography, and he underwent elective open heart surgery with implantation of a biological aortic valve, pulmonary vein ablation and left atrial appendage resection.
The heart surgery was the start of a prolonged clinical course with recurrent pleural effusion, dependent oedema and repeated admissions to the department of thoracic surgery and subsequently the department of medicine. His clinical presentation raised suspicions of heart failure. Echocardiography and right-heart catheterisation 3 months after the procedure found normal systolic and diastolic function, good function of the aortic valve and no signs of a restrictive filling pattern or pulmonary hypertension.
However, 4 months after the aortic valve surgery, cardiac MRI revealed contrast enhancement of the entire pericardium. Auscultation found a systolic murmur, interpreted as a friction sound, over the heart. CRP values had been slightly elevated during the admissions following heart surgery, mostly between 20 and 70 mg/L (reference range < 4.0). The leukocyte count was within the reference range. The patient underwent repeated pleural tap, the fluid from which had a low protein content with no microbiological findings. The patient's condition was interpreted as postcardiotomy syndrome, and treatment was started with colchicine 0.5 mg once daily and methylprednisolone 12 mg once daily. The production of pleural fluid decreased, and the patient's dyspnoea and general condition improved.
Postcardiotomy syndrome can occur following injury or heart surgery and is characterised by chest pain, dyspnoea and fever, as well as pericardial and/or pleural effusion. The incidence varies from 9 % to 40 %, depending on diagnostic criteria (1). Patients often have leukocytosis and elevated CRP and ESR. The symptoms can arise weeks or months after the initial injury (2). Colchicine, an anti-inflammatory drug that has been demonstrated to reduce the incidence of postcardiotomy syndrome following surgery (3, 4), and glucocorticoids are recommended for patients refractory to treatment (1, 5). Due to the severe clinical presentation, it was decided to start both drugs concurrently.
Six weeks after starting treatment for postcardiotomy syndrome and six months after the aortic valve surgery, the patient was admitted for the ninth time as an emergency to the department of medicine. In addition to the dyspnoea, swelling of the legs and palpitations seen in the previous admissions, he had chills and pain in the right calf and knee. He was found to be in a diminished general condition on clinical examination. He was afebrile and had normal blood pressure of 112/80 mmHg, regular pulse of 104 bpm and oxygen saturation of 95 % without oxygen administration. There were decreased bibasilar breath sounds as in pleural effusion, friction sound over the precordium, slight swelling of the right knee and an unremarkable scar following sternotomy. Unlike in previous admissions, the patient's inflammatory markers were significantly elevated with leukocytes 18.2 ×109/L (3.5–10.0 ×109), CRP 224 mg/L (< 4.0) and ESR 107 mm (< 12). Chest CT showed right-sided pleural effusion with pleural reaction, which was regarded as inflammation or infection, as well as a smaller lesion suspected to be an abscess in the right lung (Figure 1). Based on the clinical presentation and radiological suspicion of pneumonia with possible empyema, empiric treatment was initiated with cefotaxime 2 g three times daily for coverage of nosocomial aetiology. The results of bacterial culture and PCR testing of nasopharyngeal specimens for respiratory pathogens, including SARS-CoV-2, were negative.

Three days after admission, the patient complained of slurred speech, and dysarthria was noted. A CT scan and MRI of the head demonstrated lesions suspected to be abscesses in the right temporal lobe and cerebellar hemisphere (Figure 2). There was no growth in four sets of blood cultures. In accordance with Norwegian and international guidelines for the treatment of cerebral abscesses, the dose of cefotaxime was increased to 4 g three times daily with the addition of intravenous metronidazole 1.5 g once daily. Transthoracic and transoesophageal echocardiography was performed to investigate a potential embolic source, which found no evidence of endocarditis. Due to deterioration in dysarthria, four days later another MRI of the head was performed, which revealed an increase in the size of both cerebral abscesses. The following day, a neurosurgeon drained the abscess for diagnostic and therapeutic purposes, with evacuation of brownish pus. The material was sent for histological examination and culture to detect bacteria and fungi. Microscopic examination of the gram-stained specimen detected no bacteria. The specimen material was also sent for 16S rDNA sequencing.

Direct spread from a local focus accounts for 50 % of cases of central nervous system abscesses, haematogenous spread accounts for 30 %, while the spread pattern is unknown in 20 % of cases (6). Drainage is recommended if the abscess diameter is greater than 2.5 cm (7). Abscesses secondary to a local focus are commonly polybacterial with oral cavity and respiratory tract microbes (8), whereas abscesses caused by haematogenous spread are typically monobacterial (6). CT is well suited as a primary diagnostic tool if intracerebral pathology is suspected, although contrast-enhanced MRI is required to differentiate an abscess from other pathology. Diagnostic aspiration and biopsy of abscess contents should be planned in consultation with a specialist in infectious diseases, neurosurgeon and microbiologist to ensure proper and rapid handling of the specimen material. The specimen material for microbiological diagnostic examination should be prepared for microscopy on a sterile slide, both for gram and Ziehl-Neelsen staining, anaerobic and aerobic culture and mycobacterial culture. If possible, the specimen material should also be provided in blood culture medium. Lumbar puncture is of little value in cases of CNS abscesses and is associated with a risk of herniation.
Two days after abscess drainage, there was abundant growth of Nocardia species pluralis (spp.) in a specimen from the abscess contents (Figure 3). In line with international recommendations, empiric combination treatment was initiated with high-dose intravenous trimethoprim/sulfamethoxazole, 15 mg/kg divided into 3–4 doses, and imipenem 500 mg four times daily (9, 10). The treatment with colchicine and methylprednisolone was discontinued due to the drugs' immunosuppressive effect.
Nocardia spp. are strictly aerobic, gram-positive, rod-shaped bacteria. Species in the genus are often slow-growing, and prolonged incubation times (7–10 days) may be required. The microbe grew on blood agar and was visible as dry chalky-white colonies after just 2 days (Figure 3). Microscopic examination of the colonies revealed gram-positive branching filamentous rods, which were partially acid-fast on Ziehl-Neelsen staining (Figure 4). Nocardia spp. are environmental bacteria found in soil and water worldwide. There are more than 80 different Nocardia species, of which at least 30 cause disease in humans, the most common being the N. asteroides complex, N. brasiliensis and N. farcinica (11).

Species identification was performed using mass spectrometry (MALDI-TOF, matrix-assisted laser desorption/ionisation-time of flight) and 16S rDNA sequencing. In recent years, MALDI-TOF mass spectrometry has revolutionised microorganism identification. In this method, microbial proteins are fragmented and ionised by laser radiation, and the molecular mass of the free ions is detected in a vacuum chamber. The spectral protein pattern of the microbe is compared to established protein patterns from known microorganisms in a database. This leads to good species identification in most cases (12, 13). In this case, the sequencing was not able to differentiate between N. farcinica, N. kroppenstedtii and N. otitidiscaviarum, but when MALDI-TOF mass spectrometry produced repeated hits for N. farcinica, this species was considered to be the most likely cause of our patient's infection. Microbial susceptibility testing was performed using MIC gradient strips (MIC = minimum inhibitory concentration) (Liofilchem) on MH-F agar (Mueller Hinton fastidious), and the microbe was considered to be susceptible to amoxicillin/clavulanate, imipenem and trimethoprim/sulfamethoxazole (Table 1).
Table 1
Susceptibility testing from cerebral abscess in a patient with nocardiosis, performed on MH-F agar (Mueller Hinton fastidious). Based on minimum inhibitory concentration (MIC), the microbe was expected to be susceptible to amoxicillin/clavulanate, imipenem and trimethoprim/sulfamethoxazole.
| Antibiotic | MIC (mg/L) |
|---|---|
| Amikacin | 2.0 |
| Amoxicillin/clavulanate | 1.0 |
| Cefotaxime | > 32 |
| Ceftriaxone | > 32 |
| Ciprofloxacin | > 32 |
| Daptomycin | > 256 |
| Imipenem | 1.0 |
| Clarithromycin | 32 |
| Linezolid | 4.0 |
| Meropenem | 8.0 |
| Minocycline | 2.0 |
| Moxifloxacin | 2.0 |
| Tetracycline | 8.0 |
| Tobramycin | > 256 |
| Trimethoprim/sulfamethoxazole | 0.125 |
Slight swelling of the right knee was noted on admission. Increased circumference of the calf was found a few days later, as well as heat, tenderness and pain on dorsal flexion. To determine whether there were several foci of infection, a whole body PET scan was performed. This revealed enhancement around the right knee, in the right gluteus maximus muscle and below the apex of the liver, consistent with multiple abscesses. Ultrasound examination revealed a heterogeneous mass medioproximal of the knee joint and fluid accumulation in the dorsal calf. Diagnostic puncture was performed, and the specimen material sent for bacteriological testing, which again found growth of Nocardia spp., identified by MALDI-TOF mass spectrometry as N. farcinica. With abscesses in both the central nervous system and soft tissue, the patient had disseminated nocardiosis according to the definition.
Nocardiosis occurs most frequently in immunosuppressed patients after inhalation of Nocardia bacteria from the environment (10). For this reason, infection primarily develops in the lungs, where it can cause irregular nodular, potentially cavitary, lesions or infiltrates, with or without pleural effusion (11). Haematogenous spread with disseminated disease is found in 20–70 % of cases, with infection frequently developing in the central nervous system (10). Involvement of the central nervous system must always be investigated if Nocardia spp. are identified in other locations because this will have consequences for choice and duration of treatment (11). Cutaneous and soft tissue infection occurs in the context of disseminated disease and as a result of inoculation infection. T-cells are our main defence against Nocardia spp., and therefore the disease occurs most frequently in immunosuppressed transplant patients and those on glucocorticoid treatment (9).
The patient slowly responded to treatment with trimethoprim/sulfamethoxazole and imipenem, with decreasing inflammatory markers and improvement in dysarthria. Head CT scans after 5 and 8 weeks found regression of the abscesses. However, the patient had severe adverse reactions in the form of nausea and diarrhoea, and he was close to abandoning treatment on several occasions. Pharmacogenetic analysis demonstrated a genetic defect in CYP2 D19, a mutation that causes reduced metabolism of drugs including sulfamethoxazole, and thus increased adverse reactions. After 3 weeks of treatment, the dose of trimethoprim/sulfamethoxazole was reduced from 15 to 9 mg/kg/day, and the adverse reactions subsided. After 8 weeks of intravenous treatment, the antibiotics were switched to oral amoxicillin/clavulanic acid 500 mg/125 mg three times daily and trimethoprim/sulfamethoxazole 3 tablets three times daily. The planned duration of treatment was one year, with monotherapy with amoxicillin/clavulanic acid for the final 4 months.
The patient's clinical course was prolonged and challenging. The complex treatment of nocardiosis, ongoing recurrence of pleural effusion with deterioration in postcardiotomy syndrome, malnutrition and depression resulted in readmissions, and months in hospital for rehabilitation were possible. Almost 2 years after the cardiac surgery, the patient is living at home. He tires quickly, has poor appetite and experiences dyspnoea and palpitations. He has developed significant muscular atrophy, but can walk for up to one kilometre without a wheeled walker. He does daily exercises and has weekly physiotherapy. He has attended regular check-ups with specialists in cardiology, infectious diseases and respiratory medicine, as well as nutritional physiology.
Discussion
Nocardiosis is an uncommon opportunistic infection that causes severe disseminated disease.
The central nervous system is particularly affected, but all organ systems may be involved. There is no pathognomonic presentation of nocardiosis, but it should be suspected in immunosuppressed patients with nodular or cavitary lesions in the lungs and suppurative lesions in the central nervous system, skin and soft tissue. Nocardiosis probably occurred in our patient as a result of immunosuppressive glucocorticoid treatment for postcardiotomy syndrome and his weakened general condition after prolonged illness. Glucocorticoids are known to have an anti-inflammatory and immunomodulatory effect (14). Systemic treatment increases the risk of infections, and the risk increases with dose and duration of treatment, age, underlying illness and other immunomodulatory treatment (15, 16). It is less certain whether colchicine also contributed to the patient's immunosuppression. The mechanism of action of colchicine is not fully established, and there is less documentation of its immunosuppressive effect than for glucocorticoids (17).
Inoculation of Nocardia spp. during open heart surgery has not been described in the literature. The absence of local infection in the surgical site both clinically and on PET and CT scans also suggests that this was not the case in our patient. Contrast enhancement in the pleura, pleural effusion and a lesion suspected to be an abscess in the lung (Figure 1) could be due to both postcardiotomy syndrome and nocardiosis, and it was challenging to distinguish between inflammation and infection. Although we never managed to detect the microbe in pleural effusion or the respiratory tract, we assume that the lower respiratory tract was the primary focus, with further haematogenous spread to the brain and muscles of the lower extremities.
The patient received antibiotic treatment in line with international recommendations (9, 10). The mainstay of nocardiosis treatment is high-dose intravenous trimethoprim/sulfamethoxazole. In patients with severe disease, such as our patient, it may be necessary to add carbapenems, gentamicin or fluoroquinolones, depending on the susceptibility testing (10). The total duration of treatment is 3–12 months, depending on the location, severity and degree of immunosuppression. This case report is also a reminder that the detection of enzyme defects in the cytochrome P450 system may be clinically significant for both adverse effects and the efficacy of treatment.
In our patient, diagnostic imaging and good sampling of the cerebral abscess was crucial for reaching the correct diagnosis and treatment. Malignancy is a key differential diagnosis in cerebral abscess, and therefore specimens in formalin should also be sent for pathological examination. For this patient, the correct diagnosis was made after culture, but additional 16S rDNA sequencing directly on the specimen material should always be considered. PCR can detect bacteria that are difficult to culture, detect dead microbes in patients who have been treated with antibiotics prior to sampling, and enable rapid diagnosis. If Nocardia spp. is suspected, rapid identification is very important because susceptibility patterns vary between species, and it will then be possible to tailor empiric treatment (18, 19).
Conclusion
This case report illustrates that nocardiosis should be suspected in patients with abscesses and subacute infection who are on immunosuppressive treatment, including glucocorticoid treatment. Investigation of nocardiosis requires multidisciplinary collaboration, and we recommend the involvement of specialists experienced in treating the condition. Nocardiosis can be cured, but requires prolonged and high-dose antibiotic treatment.
The patient has given consent for the article to be published.
The article has been peer-reviewed.
- 1.
Lehto J, Gunn J, Karjalainen P et al. Incidence and risk factors of postpericardiotomy syndrome requiring medical attention: The Finland postpericardiotomy syndrome study. J Thorac Cardiovasc Surg 2015; 149: 1324–9. [PubMed][CrossRef]
- 2.
Lehto J, Kiviniemi T. Postpericardiotomy syndrome after cardiac surgery. Ann Med 2020; 52: 243–64. [PubMed][CrossRef]
- 3.
Imazio M, Belli R, Brucato A et al. Efficacy and safety of colchicine for treatment of multiple recurrences of pericarditis (CORP-2): a multicentre, double-blind, placebo-controlled, randomised trial. Lancet 2014; 383: 2232–7. [PubMed][CrossRef]
- 4.
Imazio M, Trinchero R, Brucato A et al. COlchicine for the Prevention of the Post-pericardiotomy Syndrome (COPPS): a multicentre, randomized, double-blind, placebo-controlled trial. Eur Heart J 2010; 31: 2749–54. [PubMed][CrossRef]
- 5.
Tamarappoo BK, Klein AL. Post-pericardiotomy Syndrome. Curr Cardiol Rep 2016; 18: 116. [PubMed][CrossRef]
- 6.
Brouwer MC, Tunkel AR, McKhann GM et al. Brain abscess. N Engl J Med 2014; 371: 447–56. [PubMed][CrossRef]
- 7.
Mamelak AN, Mampalam TJ, Obana WG et al. Improved management of multiple brain abscesses: a combined surgical and medical approach. Neurosurgery 1995; 36: 76–85, discussion 85 - 6. [PubMed][CrossRef]
- 8.
Kommedal Ø, Wilhelmsen MT, Skrede S et al. Massive parallel sequencing provides new perspectives on bacterial brain abscesses. J Clin Microbiol 2014; 52: 1990–7. [PubMed][CrossRef]
- 9.
Restrepo A, Clark NM. Nocardia infections in solid organ transplantation: Guidelines from the Infectious Diseases Community of Practice of the American Society of Transplantation. Clin Transplant 2019; 33: e13509. [PubMed][CrossRef]
- 10.
Sorell TC, Mitchell DH, Iredell JR et al. Nocardia Species. I: Mandell, Douglas and Bennett's Principles and Practice of Infectious Diseases. 8. utg. Philadelphia, PA: Elsevier, Saunders, 2015: 2853–63.
- 11.
Wilson JW. Nocardiosis: updates and clinical overview. Mayo Clin Proc 2012; 87: 403–7. [PubMed][CrossRef]
- 12.
Rollag H, Müller F, Tønjum T. Medisinsk mikrobiologi. 4. utg. Oslo: Gyldendal forlag, 2019.
- 13.
Nyberg E, Nyborg K, Liberg AM et al. MALDI-TOF MS: En mikrobiologisk revolusjon. Bioingeniøren 2015; 50: 23–6.
- 14.
Chatham WW, Kimberly RP. Treatment of lupus with corticosteroids. Lupus 2001; 10: 140–7. [PubMed][CrossRef]
- 15.
Stuck AE, Minder CE, Frey FJ. Risk of infectious complications in patients taking glucocorticosteroids. Rev Infect Dis 1989; 11: 954–63. [PubMed][CrossRef]
- 16.
Youssef J, Novosad SA, Winthrop KL. Infection risk and safety of corticosteroid use. Rheum Dis Clin North Am 2016; 42: 157–76, ix - x. [PubMed][CrossRef]
- 17.
Larsson S, Rønsted N. Reviewing Colchicaceae alkaloids - perspectives of evolution on medicinal chemistry. Curr Top Med Chem 2014; 14: 274–89. [PubMed][CrossRef]
- 18.
Glupczynski Y, Berhin C, Janssens M et al. Determination of antimicrobial susceptibility patterns of Nocardia spp. from clinical specimens by Etest. Clin Microbiol Infect 2006; 12: 905–12. [PubMed][CrossRef]
- 19.
Tan YE, Chen SC, Halliday CL. Antimicrobial susceptibility profiles and species distribution of medically relevant Nocardia species: Results from a large tertiary laboratory in Australia. J Glob Antimicrob Resist 2020; 20: 110–7. [PubMed][CrossRef]